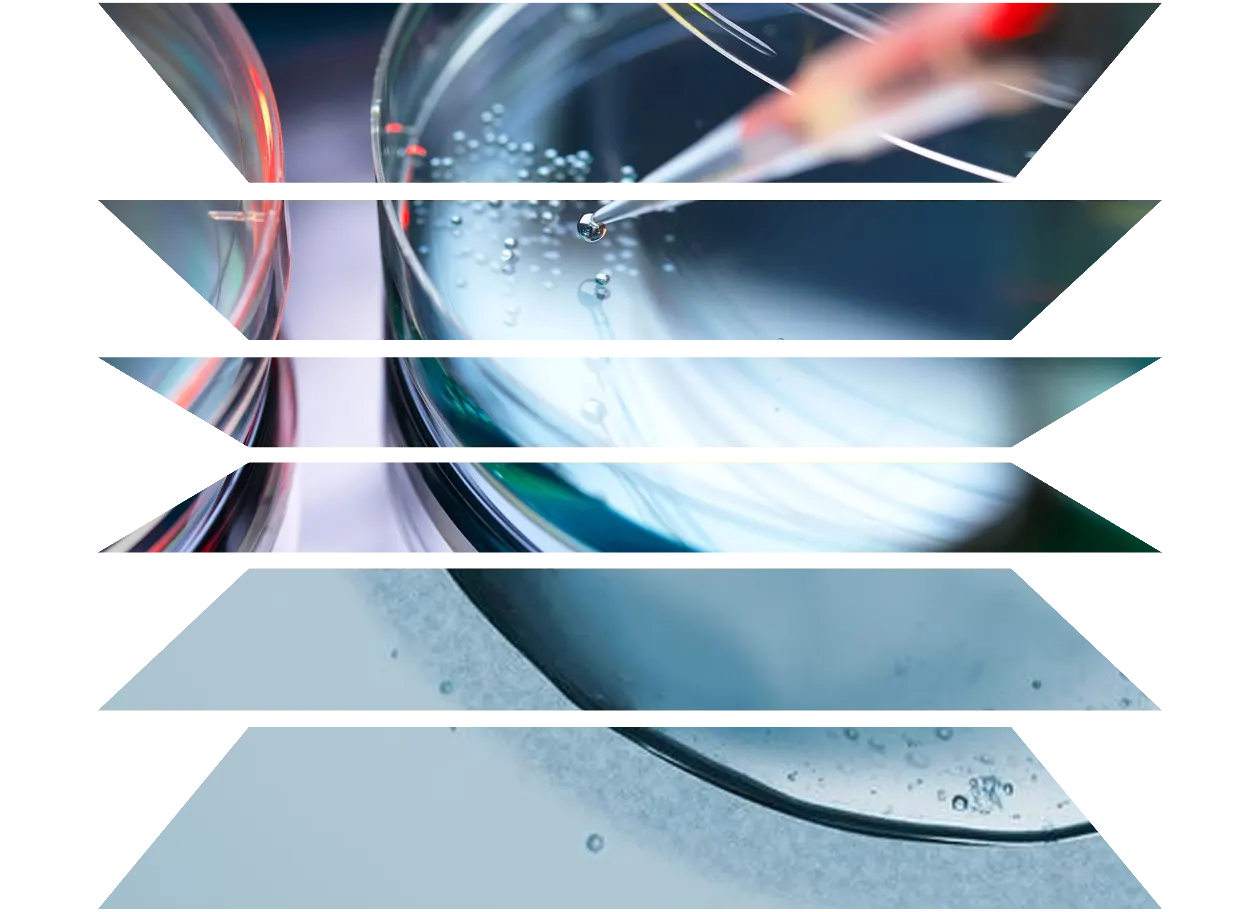
Scientist pipetting cells into a petri dish for stem cell research

The way you work with data depends on your role. From discovery to decision-making, SciBite helps everyone work from clean, connected and trusted scientific data. Examples of how we support the R&D ecosystem:
R&D leaders: Toxicologists, lab scientists, ontologists and search solutions managers who are looking to explore, connect and generate insights faster.
R&D IT leaders: Integration managers, data scientists and those working in software security focused on standardizing, governing and preparing data for analytics.
Business leaders: Budget holders, heads of innovation excellence and senior decision-makers responsible for reducing risk, maximizing ROI and progressing discovery.